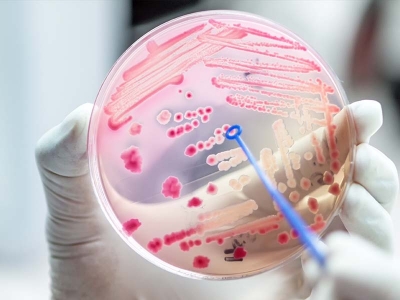
Rise of the double FELIX Logo

Raytheon -
Advances in genetic manipulation have raised the possibility of a new kind of attack on our food supply. ... The Intelligence Advanced Research Projects Activity is sponsoring the FELIX program to develop a set of tools that would help us tell the difference between a naturally occurring pathogen and one that was engineered to cause harm.